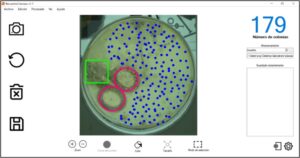
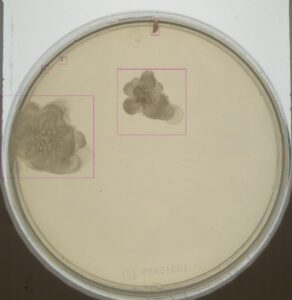

La detección de enfermedades, bacterias y microorganismos haciendo uso de tecnologías de imagen y de la inteligencia artificial es un campo en constante evolución, que, sin duda con el avance de la tecnología, y de los avances en las técnicas en inteligencia artificial, han revolucionado los diagnósticos tempranos de algunas enfermedades, y permiten al profesional encargado de supervisar dichas imágenes de una herramienta más en la que apoyarse. Te contamos algunos de los avances en este campo.
Haciendo uso de tecnologías basada en Deep Learning para el análisis de las imágenes médicas, se ha llegado a alcanzar una sensibilidad de entorno al 94% para la detección de retinopatía diabética. Una de las grandes ventajas que ofrecen estas tecnologías, frente al análisis manual por parte de un ser humano, es que, por ejemplo, la fatiga del día no le afecta, por lo tanto, supone una gran ayuda para el técnico encargado de revisar dichas imágenes.
Esto nos da una proyección global acerca del potencial de esta tecnología, y otras muchas basadas en la inteligencia artificial, para aportar información cualitativa y cuantitativa en el análisis de imagen para la detección de organismos microscópicos en imagen.
Inteligencia artificial integrada en microbiología
Desarrollar una plataforma que permita detectar y clasificar ciertos microorganismos biológicos mediante técnicas de inteligencia artificial, permite que el técnico de laboratorio, o la persona encargada de revisar dichas imágenes pueda delegar parte de su trabajo a la plataforma encargada de dicho análisis.
La solución hardware que se propone para dicho análisis, consta de una caja cerrada con una luz de fondo, y una cámara 4K de alta resolución para la adquisición de las imágenes, y un soporte para poder tomar las fotografías de las muestras en las placas Petri.
Dicha plataforma almacenará las imágenes en un banco de datos interno, y permitirá su análisis y posterior generación de resultados para que un técnico de laboratorio sea capaz posteriormente de corroborar los resultados cuando desee.
Generación del conjunto de datos de entrenamiento
Dentro de las redes neuronales supervisadas, las redes neuronales convolucionales son las que mejores resultados ofrecen para la detección de objetos (en este caso, organismos microbiológicos) en imagen.
Estas redes se construyen formando capas con filtros convolucionales de N-dimensiones, y tras cada capa se realiza un muestreo. Tras cada capa convolucional, se extraen características, y por último en la última capa de todas, compuestas por neuronas de tipo perceptrón, se clasifican los datos extraídos durante el proceso.

Este tipo de redes, aprenden en base a una primera etapa en la que se entrena el algoritmo. Cuando se habla de entrenar el algoritmo, lo que realmente se realiza es una etiquetación de los objetos que se pretenden detectar, y un ajuste de hiperparámetros.
Es por ello, que se ha dotado a la plataforma de suficiente independencia para realizar la adquisición y posterior etiquetado de la información con la que se alimentará la red neuronal.
Esta etiquetación y posterior fase de entrenamiento, hace posible que la red aprenda a distinguir los objetos de interés. En la siguiente captura se puede observar el uso de la herramienta desarrollada para la etiquetación del conjunto de datos.
Por último, el conjunto de datos seleccionado y etiquetado se divide en tres subconjuntos; uno para la fase de entrenamiento, que es el conjunto que se utiliza para entrenar la red neuronal, otro para la fase de validación, que se usa para validar los resultados mientras se entrena la red neuronal y así poder realizar un ajuste fino de los hiperparámetros, y por último para la fase de pruebas, donde se usará este último subconjunto para hacer inferencia y probar el modelo entrenado.
Normalmente, las imágenes del conjunto de datos se dividen en 60% para entrenamiento, 20% para validación, y el 20% restante para pruebas. Aunque es sujeto de cambio, y otros modelos requieren de 80%-10%-10%, según las necesidades de la propia arquitectura de red.
Experimentación y ajuste sobre imágenes reales
Una vez el conjunto de datos ha sido creado, y se ha establecido el tipo de red neuronal a aplicar como una convolucional, toca la fase de experimentación con diferentes arquitecturas de redes neuronales.
Entre las arquitecturas de redes neuronales más conocidas, y con mejores resultados para la detección de objetos, se pueden encontrar algunas como YOLO, SSD, o RetinaNet. Todas ofrecen buenos resultados para la detección de objetos previa fase de etiquetado y entrenamiento.
Estas arquitecturas de redes neuronales tienen en común que su detección se realiza en una fase. Esto significa, que en lugar de aplicar un preprocesado previo convencional haciendo uso de herramientas y algoritmos de procesado de imagen, la propia imagen en crudo es la que entra al algoritmo y se obtiene su resultado directo.
Este tipo de redes neuronales son más robustas frente a cambios en iluminación, deformaciones en imagen, y otro tipo de defectos que suelen aparecer en el tratamiento y análisis por imagen.
Fase de resultados del entrenamiento de la red neuronal
Una vez se ha hallado la mejor arquitectura de red neuronal para el problema a abordar, se entrena el sistema haciendo uso del conjunto de datos previamente seleccionado y se comprueba su eficacia en una primera iteración. Este tipo de fase, por lo general, suele ser una fase de mucha retroalimentación y ajuste de las capas e hiperparámetros para ajustar lo más finamente posible los resultados obtenidos.
Finalmente, se pueden comprobar los resultados del entrenamiento de la red neuronal, y hacer inferencia sobre imágenes reales, para obtener resultados como el mostrado a continuación.